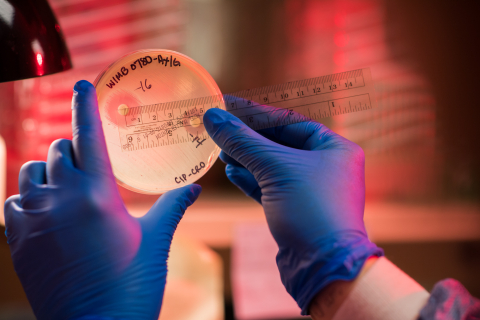
antimicrobial research

Dr. Allan Brasier arrives to lead translational research efforts at UW-Madison

Physician-scientist Allan Brasier, MD has arrived at UW-Madison from his prior position as head of the University of Texas Medical Branch Institute for Translational Sciences. He’s getting settled into the Division of Endocrinology, Metabolism and Diabetes before he takes the reins this summer as director of the UW Institute for Clinical and Translational Research (UW ICTR). During his onboarding phase, he is working with a mentor in the Department of Medicine to become familiar with the structure and resources available at UW-Madison. Serving in this mentorship role is Vincent Cryns, MD, professor, Rodney P. Burgenske Chair in Diabetes Research, and head of Endocrinology, Diabetes and Metabolism. (Dr. Brasier and Dr. Cryns are pictured together below, with Dr. Brasier on the left and Dr. Cryns on the right.)
Turnabout is fair play, it seems. “Allan was my mentor during medical school at Harvard,” said Dr. Cryns. And in another coincidence, current UW ICTR director Marc Drezner, MD, who has led the institute since it was founded in 2007, is also an endocrinologist.
His arrival has been warmly anticipated. "Dr. Brasier brings a wealth of experience in Clinical and Translational Science Awards (CTSA) leadership to his new role as the executive director of ICTR. In addition, he a physician-scientist with an active independent research program that is moving with him to Madison. We are fortunate to welcome him to our department," said Richard Page, MD,George R. and Elaine Love Professor and chair, Department of Medicine.
During Dr. Brasier’s recent travels to Washington, DC for a meeting of principal investigators for the National Institutes of Health (NIH) CTSA Program and an annual meeting of the Association for Clinical and Translational Science, he kindly responded to questions about his outlook, vision, and objectives. Below are excerpts from his interview.
 What does the phrase “translational research” mean to you personally? What attracted you to this area?
What does the phrase “translational research” mean to you personally? What attracted you to this area?
Translational research is the process by which new drugs, devices, behavioral interventions are brought into the clinic to improve the health of our patients and the residents of our state. Although this seems simple in concept, the process of translation is slow, costly and inefficient. For example, currently it takes more than two decades and several billion dollars from a drug target being discovered to bring a treatment into the clinic. And this process fails more than 90% of the time.
We have to do better than this. I have a passion for disrupting this process. One specific example has been the focus of the CTSA that I ran at the University of Texas on improving the process of team science. We developed a heuristic for translational teams that informed new approaches for training in team science and team leadership, and promoted a culture of entrepreneurship. What was fun was that we treated it as scholarship, learning from successful teams to improve our programs. This focus on continuous improvement had a significant impact on the culture and the effectiveness of team at the university. [Editor’s note: one fascinating study during Dr. Brasier’s time as director of the University of Texas Medical Branch Institute for Translational Sciences was an ethnography on the culture of translational science research that he co-authored with Joseph Kotarba, PhD, professor, Department of Sociology, UTMB.]
What are elements of translational research that you want to prioritize at UW?
What are elements of translational research that you want to prioritize at UW?
Under Dr. Drezner’s leadership, ICTR is an outstanding organization with significant strengths in training, mentorship, community engagement, improvements in protections for human subjects, and health information exchange. The leadership group is very strong and has a robust administrative presence. ICTR has broad institutional support and partnerships. And the CTSA program is highly recognized. So there is a very strong base. Over the next couple of months, I will be learning from Dr. Drezner about ICTR operations to make the transition as smooth as possible, and do not plan to make substantial changes.
ICTR is one of three sites that is participating in the All of Us Wisconsin precision medicine initiative. This is a large undertaking, and one that we need to be successful in. Among other newer areas that I will address over the intermediate term is advancing health equities research. We plan to grow the dissemination and implementation science projects in ICTR-CAP. This is a term that refers to integrating best practices in health care into the health system, and is a high yield for translation, and opportunity to provide real value to patient outcomes. We are working to advance our capabilities in both service and research in Health Informatics, which is a critical area that will support the precision medicine initiative, and planned expansion of our clinical trials capability. My expertise in team science can be used to add a dimension to our training programs. I also have substantial expertise in clinical proteomics, and there are some very strong proteomics capabilities here; I believe there is untapped potential for clinical proteomics to advance the precision medicine initiative. Translational scientists are entrepreneurial by nature, there are opportunities to get better at commercialization and entrepreneurship. We will build more robust pathways for technology and device commercialization with WARF.
What are your key measures of success?
Process improvements in health outcomes of interest to UW Health; dissemination of these improvements in care providers throughout the state; integration of health informatics in clinical research programs growth of team sciences-based program projects, NIH U01 grants (Research Project Cooperative Agreements) and center grants; and commercialization of new biomarkers of disease.
Given the historical ties between translational research at UW and endocrinology – do you think this is a coincidence, or is there an aspect of endocrinology that lends itself well to translational research?
It’s a striking coincidence that Dr. Drezner and I are both endocrinologists. Endocrinology has been historically a research intensive, systems level sub-specialty. For example, disorders of thyroid hormone metabolism affects cognition, cardiovascular function, metabolic pathways and the skeletal system that produce differences in the manifestations of the disease. Maybe this systems level thinking lends itself to interest in leading complex organizations with multiple outputs.
 What message would you like to convey for PIs, trainees, and staff who are not currently involved in translational research?
What message would you like to convey for PIs, trainees, and staff who are not currently involved in translational research?
I would be hard pressed to identify any problem in biological science that wouldn’t have some translational angle. I would like to UW scientists see ICTR as the first place to go to get help in advancing multi-component studies, improving in study design, developing community collaborations, enhancing the effectiveness of their teams, addressing regulatory roadblocks commercializing their discoveries.
Hobbies/interests you pursue outside of work?
I am an avid tennis player and do a lot of cross training with my triathlete wife, Anne.
Any good stories to share about Dr. Cryns from your time as his medical school mentor?
I recall he stood out by his bowtie selection! He was a star student, and I am not surprised to see how successful he has been in academic medicine.
Resources:
- "Allan Brasier to Lead Institute for Clinical and Translational Research," UW School of Medicine and Public Health, January 24, 2018